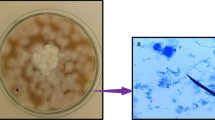

Abstract
ATTEMPTS are now being made to apply to other pests the sterile male technique, so successful in the suppression of the screw-worm fly Cochliomyia hominivorax in the southern United States. There is, however, a need to devise similar methods which may be even more appropriate in particular cases. One such method which is similar to, but simpler than, the “booby-trapping” method of Morgan1 was suggested as a result of experiments with the Australian sheep blowfly, Lucilia cuprina. Female flies, resistant to dieldrin, which survived 0.5 µl. of 2 per cent dieldrin dissolved in kerosene and di-isobutyl ketone (1 : 1) applied topically to the thorax, were exposed to males from a susceptible strain (LD50< 0.005 per cent dieldrin). Each female killed up to one hundred males through contact during attempted mating. Treated resistant males were capable of killing susceptible females, but the effect was of a lower order of magnitude.
This is a preview of subscription content, access via your institution
Access options
Subscribe to this journal
Receive 51 print issues and online access
$199.00 per year
only $3.90 per issue
Buy this article
- Purchase on SpringerLink
- Instant access to full article PDF
Prices may be subject to local taxes which are calculated during checkout
Similar content being viewed by others
References
Morgan, P. B., J. Econ. Entomol., 60, 612 (1967).
Crow, J. F., Ann. Rev. Entomol., 2 (1957).
Author information
Authors and Affiliations
Rights and permissions
About this article
Cite this article
WHITTEN, M., NORRIS, K. “Booby-trapping” as an Alternative to Sterile Males for Insect Control. Nature 216, 1136 (1967). https://doi.org/10.1038/2161136a0
Received:
Published:
Issue date:
DOI: https://doi.org/10.1038/2161136a0